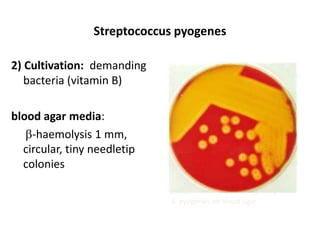
Streptococcus pyogenes
2) Cultivation: demanding
bacteria (vitamin B)
blood agar media:
-haemolysis 1 mm,
circular, tiny needletip
colonies
S. pyogenes on blood agar

This document summarizes information about Staphylococci and Streptococci bacteria. It discusses their microscopic morphology, cultivation characteristics, biochemical features, virulence factors, clinical presentations, and treatment. Key points include:
- Staphylococci are Gram-positive cocci that can be coagulase-positive like S. aureus or coagulase-negative like S. epidermidis. S. aureus is an important human pathogen able to cause both localized and invasive infections.
- Streptococci are Gram-positive cocci arranged in chains. Important species include S. pyogenes (Group A Strep) which causes pharyngitis and can lead to post-stre